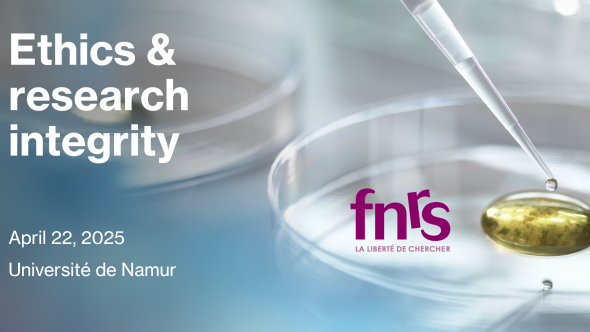
Visuel ethics and integrity et logo FNRS

Ethics and research integrity
The FNRS Graduate School in Cellular and Molecular Biology, and Biochemistry (EDT-BCMB) is pleased to invite you to a half-day dedicated to ethics and research integrity.

The FNRS Graduate School in Cellular and Molecular Biology, and Biochemistry (EDT-BCMB) is pleased to invite you to a half-day dedicated to ethics and research integrity.
Our guest lecturer will be Xavier Coumoul, Professor of Toxicology and Biochemistry at Université Paris Cité.
09:00 - 09:30 Welcome coffee
09:30 - 10:30 LECTURE | Science on the Edge: The Perils and Ethics of Research Integrity
10:45 - 12:15 WORKSHOP | Science Under Scrutiny: The Dos and Don’ts of Ethical Research
This workshop explores the fundamental principles of scientific integrity and research ethics, addressing key challenges and best practices to ensure ethical research conduct. The Key Topics that may be covered:
With an interactive approach, the session encourages participants to critically analyze scientific integrity and develop strategies to maintain ethical standards in their work.
Participation is free, but registration is mandatory. Registration deadline : April 15, 2025.
PhD students will receive certificates of attendance to validate doctoral training credits.